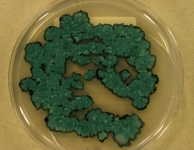

<< back to search
IMAGES:

Search Details
add to cart
| UAMH Number: | 11655 |
|---|---|
| Species Name: | Chlorociboria aeruginascens |
| Type: | |
| Synonyms: | Chlorosplenium aeruginascens / Chlorosplenium aeruginosum var. aeruginascens / Peziza aeruginascens |
| Taxonomy: | FUNGI Ascomycota, Leotiomycetes, Helotiales, Chlorociboriaceae |
| Strain History: | Tudor, D (DT8315) -> UAMH |
| Substrate: | on decaying hardwood log | Location: | CANADA Ontario, Haliburton County, Haliburton, Haliburton Forest (GEO: 45.052,-78.523) |
| Isolator: | D. Tudor |
| Isolation Date: | 2011-06-01 |
| Date Received: | 2012-07-26 |
| Characters: | APPLICATION stimulating growth and xylindein pigment on malt agar with wood additives - Robinson SC, Tudor D, Snider H, Cooper PA, AMB Express 2:15, 2012 // CULTURE CONDITIONS colonies dark blue green on 2% MEA - // CULTURE CONDITIONS phialidic conidia observed in culture - // PIGMENT blue-green (xylindein) - // PIGMENT produces yellow-green pigment at acidic pH and dark green pigment at neurtral pH - Tudor D et al 2013 (Click for publications citing UAMH 11655) |
| Compounds: | |
| Cross Reference: | TRTC 167754 |
| Collections: | Living Strains; Dried Herbarium Material |
| Pathogenic Potential: | Human: no | Animal: no | Plant: yes |
| Biosafety Risk Group: | RG1 (check the PHAC ePATHogen Risk Group Database for updates) |
| Regulatory Requirements: | No restrictions for Canadian requesters. International requesters must provide all legally required importation documentation prior to shipment. Plant pathogenicity status may be verified by using the USDA Agricultural Research Service (ARS) Fungal Database |
| MycoBank ID: | 285167 |
| Sequences: | >UAMH11655_JX843711_ITS CATTACAGAGTTCGTGCCCGCCTGGGTAGATCTCCCACCCGTGACATCTCACACCTTTGTTGCTTTGGCGGGCTTGTGGCCCTGCTGCTGCCCGCCAGAGGCCCCCAACTCAGTAATTTTAGTGTCGTCTGAGTCCTACAAAATAGTTAAAACTTTCAACAACGGATCTCTTGGTTCTGGCATCGATGAAGAACGCAGCGAAATGCGATAAGTAATGTGAATTGCAGAATTTAGTGAATCATCGAATCTTTGAACGCACATTGCGCCCTATGGTATTCCGTAGGGCATGCCTGTTCGAGCGTCATTGCAACCCTCAAGCGCTGCTTGGTCTTGGGCCCGCCTGCTGGGCGAGCCCCAAATACAGTGGTAGTGCTCCCCGGCCCTGAGCGTAGTACATCACCCGCTACAGGGCCTGGGGAACCGCGAGCCAAGCAATTTTTACCCCTCAAGGTTGACCT |
IMAGES:




